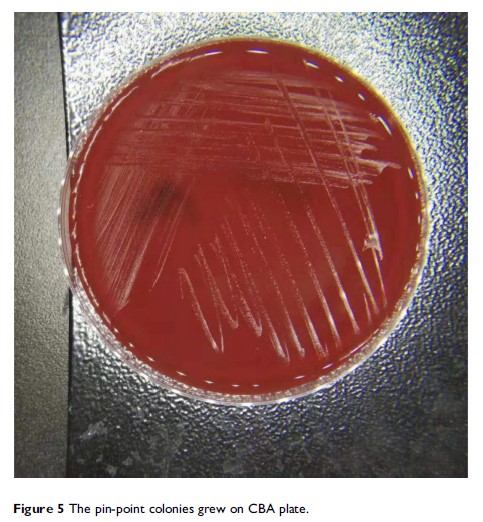

-
Origianl Research

- 作者:Shu Zhao, Mengqi Sun, Hongxue Meng, Hongfei Ji, Yupeng Liu, Minghui Zhang, Hongbin Li, Pengfei Li, Yue Zhang, Qingyuan Zhang
- 期刊:Cancer Management and Research
-
Origianl Research

- 作者:Ningbo Fan, Dongni Chen, Jiabo Zheng, Zhesheng Wen, Peng Lin
- 期刊:Cancer Management and Research
-
Review

- 作者:Yilan Sun, Jianying Zhou
- 期刊:International Journal of Chronic Obstructive Pulmonary Disease
-
Review

- 作者:Yiqun Han, Jiayu Wang, Weiming Liu, Peng Yuan, Qing Li, Pin Zhang, Fei Ma, Yang Luo, Ying Fan, Shanshan Chen, Ruigang Cai, Qiao Li, Binghe Xu
- 期刊:Cancer Management and Research
-
Case Report
- 作者:Nan Xiao, Wei Gai, Wei-Guo Hu, Jian-Xing Li, Yan Zhang, Xiu-Ying Zhao
- 期刊:Infection and Drug Resistance
-
Case Report

- 作者:Mei-Fang Wang, Li Wang, Lin-Feng Li
- 期刊:Infection and Drug Resistance